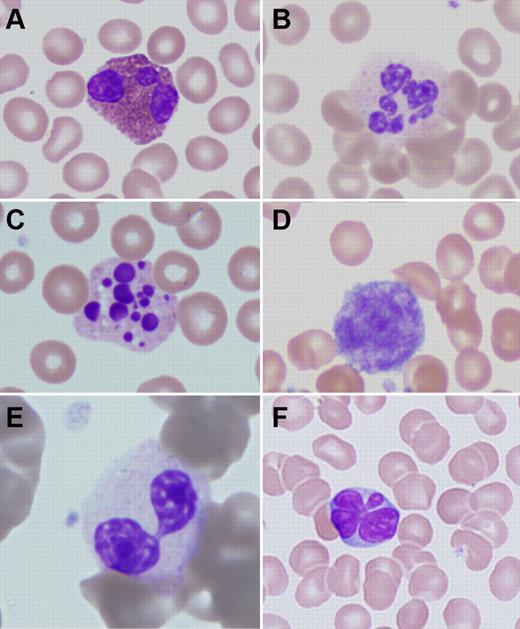
Figure 1. Peripheral blood abnormalities in patients with ADA-SCID. (A) Trilobed eosinophil from patient ADA1. (B) Hyperlobular neutrophil from patient ADA14. (C) Pyknotic neutrophil from patient ADA3. (D) Giant platelet from patient ADA14. (E) Pseudo-Pelger-Hüet cell from patient ADA16. (F) Atypical lymphocyte from patient ADA10. Slides were stained with Wright-Giemsa. Images were obtained via digital microscopy using an Olympus BX-51 microscope equipped with a DPlan 40×/0.65 numeric aperture objective and captured using an Olympus DP70 digital camera system. Microsoft PowerPoint was used to assemble the panels into 1 figure. (A-F) Original magnification ×1000.

Abstract
Genetic deficiency of adenosine deaminase (ADA) can cause profound lymphopenia and result in the clinical presentation of severe combined immune deficiency (SCID). However, because of the ubiquitous expression of ADA, ADA-deficient patients often present also with nonimmunologic clinical problems, affecting the skeletal, central nervous, endocrine, and gastrointestinal systems. We now report that myeloid dysplasia features and bone marrow hypocellularity are often found in patients with ADA-SCID. As a clinical correlate to this finding, we have observed vulnerability to antibiotic-induced myelotoxicity and prolonged neutropenia after nonmyeloablative chemotherapy. We have also noted that, in the absence of enzyme replacement therapy, absolute neutrophil counts of patients with ADA deficiency vary inversely with the accumulation of deoxynucleotides. These data have significant implications for the application of standard and investigational therapies to patients with ADA-SCID and support further studies to investigate the possibility that ADA deficiency is associated with a stem cell defect. These trials were registered at www.clinicaltrials.gov as #NCT00018018 and #NCT00006319.
Introduction
Adenosine deaminase (ADA) deficiency is a rare form of severe combined immune deficiency (SCID) characterized by profoundly diminished T-cell, B-cell, and NK-cell numbers.1,2 Similar to other SCIDs, ADA-SCID is a life-threatening disease because of extreme susceptibility to recurrent and overwhelming infections. However, ADA-SCID differs from most other immune deficiency disorders because of the metabolic effect of ADA deficiency beyond the immune system.
Indeed, a number of nonlymphoid phenotypes complicate the clinical presentation of ADA-SCID. Many such patients have sensorineural hearing loss3 or other neurocognitive syndromes.4 In addition, ADA-SCID has been associated with pathologic and/or clinical findings involving various organs, including the skeleton, kidney, adrenal gland, liver, and central nervous system,4-7 although it has been challenging to clearly delineate the potential roles of the enzymatic defect and possible unrecognized infections in the etiology of some of these features. Other nonlymphoid phenotypes that we have recently observed include susceptibility to dermatofibrosarcoma protuberans8 and trisomy 8, observed in one ADA-SCID patient.9
Several forms of treatment are available for ADA-SCID, including allogeneic hematopoietic stem cell transplantation, enzyme replacement therapy with pegylated bovine ADA (PEG-ADA), and gene therapy.10,11 All management options have been proven able to improve survival of affected patients, allowing nonimmunologic phenotypes because of ADA deficiency to become more apparent and potentially clinically important. We and others11,12 have described prolonged cytopenias after nonmyeloablative chemotherapy administered in conjunction with gene therapy in patients with ADA-SCID. We now describe a series of previously unrecognized dysplastic changes and hypocellularity in the bone marrow of ADA-deficient patients. Of note, these findings have been identified in patients before and after chemotherapy, as well as in subjects who have only been treated with PEG-ADA and supportive care. These observations have been associated with clinically significant sequelae, making their recognition of importance both to the care of patients with ADA-SCID and to the understanding of the biology of ADA deficiency.
Methods
Patients
All investigations were approved by the Institutional Review Board of the National Human Genome Research Institute. Patients were followed and treated at the National Institutes of Health Clinical Research Center under clinical research protocols registered at www.clinicaltrials.gov as #NCT00018018 and #NCT00006319.
Blood counts and histomorphologic analysis
Routine blood counts were performed on either an Abbott Sapphire or a Sysmex hematology analyzer. Peripheral blood smears were subjected to routine examination after Wright-Giemsa staining. Four-micron-thick sections of bone marrow trephine biopsies were cut and stained with hematoxylin and eosin using standard procedures. Aspirate smears were stained with Wright-Giemsa also using standard procedures. Bone marrow biopsy reticulin staining was performed using a Nexes automated special stainer (Ventana Medical Systems) according to the manufacturer's instructions. Images were obtained via digital microscopy using an Olympus BX-51 microscope (Olympus America) equipped with a DPlan 40×/0.65 numeric aperture objective and captured using an Olympus DP70 digital camera system. Imaging software was Adobe Photoshop CS3 (Adobe Systems) and Microsoft PowerPoint.
Purine metabolic profile
ADA enzymatic activity and the levels of total adenosine and deoxyadenosine nucleotides (AXP and dAXP, respectively) in peripheral blood samples were measured at Duke University Medical Center as previously described.13 For the purpose of comparing levels in different patients determined at various times, the level of erythrocyte dAXP is expressed as the percentage of total adenine nucleotides (ie, % dAXP =[dAXP]/[AXP + dAXP] × 100).
Statistics
Linear regression was performed using Prism Version 5.0 (GraphPad Software).
Results
Cell counts and marrow dysplasia at baseline
Thirteen patients were evaluated for this study. The average age was 8.8 years (range, 1-27). Clinical details from the first routine follow-up visit after initiation of this study are presented in Table 1. Although some of the patients had received hematopoietic cell transplantation years before their assessment, none had sustained myeloid engraftment. Similarly, some patients had had gene therapy with minimal or no conditioning with busulfan (0-90 mg/m2), but no patient had > 1% marking in peripheral blood cells. All of the reported hematologic parameters were obtained months to years after gene therapy, when the effects of low-dose busulfan conditioning would have resolved. Peripheral blood smears of all patients, obtained in the course of routine care or to evaluate abnormalities of the complete blood count, showed atypical changes in nonlymphoid cells (Table 2). Again, these findings were made months to years after stem cell transplantation or gene therapy. Changes were seen both in patients with normal and abnormal white blood cell counts. There were several characteristic morphologic findings. Almost all patients had large/giant platelets. The majority of patients had some hypogranular or vacuolated neutrophils. In 2 cases, pseudo-Pelger-Hüet neutrophils were observed. On occasion, hyperlobular neutrophils were also seen. In 7 cases, there were circulating pyknotic neutrophils. All cases had mildly atypical eosinophils, most notably showing cytoplasmic vacuoles, uneven granulation, or hyperlobular nuclei. Changes in eosinophils were present whether or not the patients had relative or absolute eosinophilia (Figure 1).
Clinical details of the patients studied
| Patient no. . | Age, y . | Sex . | Previous treatment(s) . | Conditioning before cellular therapy . | Current therapy . | Hemoglobin, g/dL . | Platelets/μL . | WBC, cells/μL . | Differential . |
|---|---|---|---|---|---|---|---|---|---|
| ADA1 | 23 | Female | PEG-ADA, T-lymphocyte gene therapy | None | PEG-ADA, TMP/SFX | 13.4 | 242 000 | 4810 | N 67.6%, L 11.4%, M 12.9%, E 7.3%, B 0.8% |
| ADA3 | 12 | Male | Haploidentical HCT | None | PEG-ADA, IVIG, TMP/SFX | 13.9 | 383 000 | 3790 | N 79.4%, L 9.0%, M 9.5%, E 1.8%, B 0.3% |
| ADA4 | 9 | Male | Haploidentical HCT | None | PEG-ADA, IVIG, TMP/SFX | 12.2 | 235 000 | 1730 | N 47.5%, L 21.3%, M 25.5%, E 5.7%, B 0.0% |
| ADA5 | 7 | Male | PEG-ADA, HSC gene therapy | Busulfan 90 mg/m2 | SCIG, Pentamidine | 11.5 | 319 000 | 4680 | N 72.7%, L 6.4%, M 13.7%, E 5.6%, B 1.5% |
| ADA6 | 6 | Male | Haploidentical HCT | None | PEG-ADA, SCIG, TMP/SFX, itraconazole | 11.2 | 425 000 | 4000 | N 45.0%, L 3.0%, M 5.0%, E 46.0%, B 1.0% |
| ADA7 | 6 | Male | Haploidentical HCT | None | PEG-ADA, IVIG, TMP/SFX | 13.5 | 453 000 | 7490 | N 70.0%, L 5.6%, M 8.2%, E 14.9%, B 1.4% |
| ADA9 | 3 | Male | None | NA | PEG-ADA, SCIG, TMP/SFX, Acyclovir | 13.5 | 277 000 | 6180 | N 20.4%, L 61.3%, M 14.7%, E 2.8%, B 0.8% |
| ADA10 | 2 | Male | HSC gene therapy | Busulfan 90 mg/m2 | PEG-ADA, IVIG, TMP/SFX | 11.2 | 267 000 | 1020 | N 31.4%, L 13.7%, M 8.8%, E 45.1%, B 1.0% |
| ADA12 | 12 | Female | HSC gene therapy | None | PEG-ADA, IVIG, TMP/SFX | 14.8 | 326 000 | 5120 | N 74.2%, L 5.7%, M 8.3%, E 11.4%, B 0.4% |
| ADA13 | 27 | Female | PEG-ADA, T-lymphocyte gene therapy, HSC gene therapy | None | PEG-ADA | 13.1 | 290 000 | 3340 | N 71.2%, L 8.7%, M 11.3%, E 8.8%, B 0.0% |
| ADA14 | 3 | Female | PEG-ADA, HSC gene therapy | Busulfan 75 mg/m2 | IVIG, TMP/SFX, itraconazole, acyclovir | 13.2 | 262 000 | 2280 | N 71.0%, L 7.0%, M 17.0%, E 3.0%, B 2.0% |
| ADA16 | 4 | Male | PEG-ADA, HSC gene therapy | Busulfan 75 mg/m2 | acyclovir, TMP/SFX | 12.3 | 293 000 | 2670 | N 60.0%, L 5.0%, M 13.0%, E 12.0%, B 2.0% V8.0% |
| ADA18 | 5 | Female | None | NA | PEG-ADA, TMP/SFX | 11.8 | 252 000 | 5040 | N 72.3%, L 8.3%, M 7.1%, E 12.1%, B 0.2% |
| Patient no. . | Age, y . | Sex . | Previous treatment(s) . | Conditioning before cellular therapy . | Current therapy . | Hemoglobin, g/dL . | Platelets/μL . | WBC, cells/μL . | Differential . |
|---|---|---|---|---|---|---|---|---|---|
| ADA1 | 23 | Female | PEG-ADA, T-lymphocyte gene therapy | None | PEG-ADA, TMP/SFX | 13.4 | 242 000 | 4810 | N 67.6%, L 11.4%, M 12.9%, E 7.3%, B 0.8% |
| ADA3 | 12 | Male | Haploidentical HCT | None | PEG-ADA, IVIG, TMP/SFX | 13.9 | 383 000 | 3790 | N 79.4%, L 9.0%, M 9.5%, E 1.8%, B 0.3% |
| ADA4 | 9 | Male | Haploidentical HCT | None | PEG-ADA, IVIG, TMP/SFX | 12.2 | 235 000 | 1730 | N 47.5%, L 21.3%, M 25.5%, E 5.7%, B 0.0% |
| ADA5 | 7 | Male | PEG-ADA, HSC gene therapy | Busulfan 90 mg/m2 | SCIG, Pentamidine | 11.5 | 319 000 | 4680 | N 72.7%, L 6.4%, M 13.7%, E 5.6%, B 1.5% |
| ADA6 | 6 | Male | Haploidentical HCT | None | PEG-ADA, SCIG, TMP/SFX, itraconazole | 11.2 | 425 000 | 4000 | N 45.0%, L 3.0%, M 5.0%, E 46.0%, B 1.0% |
| ADA7 | 6 | Male | Haploidentical HCT | None | PEG-ADA, IVIG, TMP/SFX | 13.5 | 453 000 | 7490 | N 70.0%, L 5.6%, M 8.2%, E 14.9%, B 1.4% |
| ADA9 | 3 | Male | None | NA | PEG-ADA, SCIG, TMP/SFX, Acyclovir | 13.5 | 277 000 | 6180 | N 20.4%, L 61.3%, M 14.7%, E 2.8%, B 0.8% |
| ADA10 | 2 | Male | HSC gene therapy | Busulfan 90 mg/m2 | PEG-ADA, IVIG, TMP/SFX | 11.2 | 267 000 | 1020 | N 31.4%, L 13.7%, M 8.8%, E 45.1%, B 1.0% |
| ADA12 | 12 | Female | HSC gene therapy | None | PEG-ADA, IVIG, TMP/SFX | 14.8 | 326 000 | 5120 | N 74.2%, L 5.7%, M 8.3%, E 11.4%, B 0.4% |
| ADA13 | 27 | Female | PEG-ADA, T-lymphocyte gene therapy, HSC gene therapy | None | PEG-ADA | 13.1 | 290 000 | 3340 | N 71.2%, L 8.7%, M 11.3%, E 8.8%, B 0.0% |
| ADA14 | 3 | Female | PEG-ADA, HSC gene therapy | Busulfan 75 mg/m2 | IVIG, TMP/SFX, itraconazole, acyclovir | 13.2 | 262 000 | 2280 | N 71.0%, L 7.0%, M 17.0%, E 3.0%, B 2.0% |
| ADA16 | 4 | Male | PEG-ADA, HSC gene therapy | Busulfan 75 mg/m2 | acyclovir, TMP/SFX | 12.3 | 293 000 | 2670 | N 60.0%, L 5.0%, M 13.0%, E 12.0%, B 2.0% V8.0% |
| ADA18 | 5 | Female | None | NA | PEG-ADA, TMP/SFX | 11.8 | 252 000 | 5040 | N 72.3%, L 8.3%, M 7.1%, E 12.1%, B 0.2% |
HCT indicates hematopoietic cell transplantation; HSC, hematopoietic stem cell; PEG-ADA, pegylated bovine adenosine deaminase; TMP/SFX, trimethoprim/sulfamethoxazole; IVIG, intravenous immunoglobulin; NA, not applicable, SCIG, subcutaneous immunoglobulin; WBC, white blood cells; N, neutrophils; L, lymphocytes; M, monocytes; E, eosinophils; B, basophils; and V, variant lymphocytes.
Peripheral blood findings
| Patient no. . | Platelets . | Neutrophils . | Eosinophils . |
|---|---|---|---|
| ADA1 | Large, rare giant | Rare hypogranular, rare pseudo-Pelger-Hüet, toxic granules | Hypersegmented |
| ADA3 | Giant | Rare hypogranular, rare pyknotic | NA |
| ADA4 | Rare large, rare giant | Rare hypogranular | Hypersegmented |
| ADA5 | Large, rare giant | Rare hypogranular, pyknotic, hypersegmented | Rare hypogranular, hypersegmented |
| ADA6 | Giant | Rare hypogranular, vacuolated | Increased, hypersegmented, rare hypogranular |
| ADA7 | Giant | Rare hypogranular | Rare hypogranular, hypersegmented |
| ADA9 | Large, giant | NA | NA |
| ADA10 | Large, rare giant | Hypogranular, vacuolated | Rare hypogranular, hypersegmented |
| ADA12 | Rare giant | Hypogranular, rare pyknotic | Rare hypogranular, hypersegmented |
| ADA13 | Large, rare giant | Hypogranular, rare pyknotic | Hypogranular, hypersegmented |
| ADA14 | Large, rare giant | Rare hypogranular, rare pyknotic, rare vacuolated | Hypogranular, hypersegmented |
| ADA16 | Large, rare giant | Rare pyknotic, rare pseudo-Pelger-Hüet, vacuolated | Hypersegmented |
| ADA18 | Rare giant | Rare pyknotic | NA |
| Patient no. . | Platelets . | Neutrophils . | Eosinophils . |
|---|---|---|---|
| ADA1 | Large, rare giant | Rare hypogranular, rare pseudo-Pelger-Hüet, toxic granules | Hypersegmented |
| ADA3 | Giant | Rare hypogranular, rare pyknotic | NA |
| ADA4 | Rare large, rare giant | Rare hypogranular | Hypersegmented |
| ADA5 | Large, rare giant | Rare hypogranular, pyknotic, hypersegmented | Rare hypogranular, hypersegmented |
| ADA6 | Giant | Rare hypogranular, vacuolated | Increased, hypersegmented, rare hypogranular |
| ADA7 | Giant | Rare hypogranular | Rare hypogranular, hypersegmented |
| ADA9 | Large, giant | NA | NA |
| ADA10 | Large, rare giant | Hypogranular, vacuolated | Rare hypogranular, hypersegmented |
| ADA12 | Rare giant | Hypogranular, rare pyknotic | Rare hypogranular, hypersegmented |
| ADA13 | Large, rare giant | Hypogranular, rare pyknotic | Hypogranular, hypersegmented |
| ADA14 | Large, rare giant | Rare hypogranular, rare pyknotic, rare vacuolated | Hypogranular, hypersegmented |
| ADA16 | Large, rare giant | Rare pyknotic, rare pseudo-Pelger-Hüet, vacuolated | Hypersegmented |
| ADA18 | Rare giant | Rare pyknotic | NA |
NA indicates not applicable.
Peripheral blood abnormalities in patients with ADA-SCID. (A) Trilobed eosinophil from patient ADA1. (B) Hyperlobular neutrophil from patient ADA14. (C) Pyknotic neutrophil from patient ADA3. (D) Giant platelet from patient ADA14. (E) Pseudo-Pelger-Hüet cell from patient ADA16. (F) Atypical lymphocyte from patient ADA10. Slides were stained with Wright-Giemsa. Images were obtained via digital microscopy using an Olympus BX-51 microscope equipped with a DPlan 40×/0.65 numeric aperture objective and captured using an Olympus DP70 digital camera system. Microsoft PowerPoint was used to assemble the panels into 1 figure. (A-F) Original magnification ×1000.
Peripheral blood abnormalities in patients with ADA-SCID. (A) Trilobed eosinophil from patient ADA1. (B) Hyperlobular neutrophil from patient ADA14. (C) Pyknotic neutrophil from patient ADA3. (D) Giant platelet from patient ADA14. (E) Pseudo-Pelger-Hüet cell from patient ADA16. (F) Atypical lymphocyte from patient ADA10. Slides were stained with Wright-Giemsa. Images were obtained via digital microscopy using an Olympus BX-51 microscope equipped with a DPlan 40×/0.65 numeric aperture objective and captured using an Olympus DP70 digital camera system. Microsoft PowerPoint was used to assemble the panels into 1 figure. (A-F) Original magnification ×1000.
To control for the effect of trimethoprim/sulfamethoxazole on cell morphology, peripheral blood smears from patients treated with this drug after allogeneic transplantation for hematologic malignancy were evaluated, and similar changes were not found (data not shown).
Six patients underwent bone marrow examination to further evaluate peripheral blood abnormalities (Table 3). In all cases, bone marrows were hypocellular for age. The percentage cellularity appeared to decrease with age. In the most extreme example (ADA1), bone marrow biopsy performed at the age of 21 years revealed 20% cellularity with trilineage hypoplasia (Figure 2A). In this patient, decline in the myeloid lineage was more severe than in the erythroid lineage, revealing mild erythroid predominance. In addition, granulocytic maturation was mildly left-shifted and there was an increase in monocytic precursors. Patient ADA5 had hypocellular marrow, left-shifted eosinophilopoiesis, and small hypolobulated megakaryocytes.
Bone marrow findings
| Patient no. . | Age at biopsy . | Bone marrow cellularity, % . | M:E ratio . | Granulocytic series . | Erythroid series . | Megakaryocytes . | Eosinophils . | Monocytic precursors . | Other . |
|---|---|---|---|---|---|---|---|---|---|
| ADA1 | 21 y | 20 | 2:1 | Mild left shift | Megaloblastic | Hypolobated | Mild increase | Mild increase | NA |
| ADA5 | 8 y | 30 | 1:1 | Normal | Normal | Small, hypolobulated | Left-shifted | Normal | NA |
| ADA6 | 6 y | 30-40 | 1:1 | Left shift | Megaloblastic | Normal | Increased, left-shifted | Mild increase | NA |
| ADA10 | 16 mo | 60 | 1:1 | Left shift, megaloblastic, rare pseudo-Pelger-Hüet cells | Normal | Monolobated, micromegakaryocytes | Left-shifted | Normal | Paratrabecular fibrosis, increased hematogones |
| ADA14 | 2.5 y | 50 | 2-1:1 | Mild left shift | Megaloblastic | Few hypolobated | Normal | Mild increase | Increased hematogones |
| ADA16 | 2 y | NA | NA | Mild left shift | Megaloblastic, rare nuclear budding | Hypolobated, monolobated | Left-shifted | Mild increase | NA |
| Patient no. . | Age at biopsy . | Bone marrow cellularity, % . | M:E ratio . | Granulocytic series . | Erythroid series . | Megakaryocytes . | Eosinophils . | Monocytic precursors . | Other . |
|---|---|---|---|---|---|---|---|---|---|
| ADA1 | 21 y | 20 | 2:1 | Mild left shift | Megaloblastic | Hypolobated | Mild increase | Mild increase | NA |
| ADA5 | 8 y | 30 | 1:1 | Normal | Normal | Small, hypolobulated | Left-shifted | Normal | NA |
| ADA6 | 6 y | 30-40 | 1:1 | Left shift | Megaloblastic | Normal | Increased, left-shifted | Mild increase | NA |
| ADA10 | 16 mo | 60 | 1:1 | Left shift, megaloblastic, rare pseudo-Pelger-Hüet cells | Normal | Monolobated, micromegakaryocytes | Left-shifted | Normal | Paratrabecular fibrosis, increased hematogones |
| ADA14 | 2.5 y | 50 | 2-1:1 | Mild left shift | Megaloblastic | Few hypolobated | Normal | Mild increase | Increased hematogones |
| ADA16 | 2 y | NA | NA | Mild left shift | Megaloblastic, rare nuclear budding | Hypolobated, monolobated | Left-shifted | Mild increase | NA |
NA indicates not applicable; and M:E, myeloid:erythroid.
Bone marrow abnormalities in patients with ADA-SCID. (A) Hypocellular biopsy from patient ADA1 at 21 years of age. (B) Left-shifted eosinophilia in patient ADA6. (C) Atypical, mononuclear megakaryocytes in a clot section from patient ADA16. (D) Dysplastic megakaryocyte with separated nuclear lobes in patient ADA6. (E) Area of atypical fibrosis in the marrow biopsy of patient ADA10. (F) Hypogranular granulocytic precursor and megaloblastoid erythroid precursor (arrows) in the marrow aspirate of patient ADA10. Biopsies were stained with hematoxylin and eosin and aspirates with Wright-Giemsa. Images were obtained via digital microscopy using an Olympus BX-51 microscope equipped with a DPlan 40×/0.65 numeric aperture objective and captured using an Olympus DP70 digital camera system. Adobe Photoshop CS3 was used to assemble the panels into one figure. (A,E) Original magnification ×40. (B,D,F) Original magnification ×1000. (C) Original magnification ×200.
Bone marrow abnormalities in patients with ADA-SCID. (A) Hypocellular biopsy from patient ADA1 at 21 years of age. (B) Left-shifted eosinophilia in patient ADA6. (C) Atypical, mononuclear megakaryocytes in a clot section from patient ADA16. (D) Dysplastic megakaryocyte with separated nuclear lobes in patient ADA6. (E) Area of atypical fibrosis in the marrow biopsy of patient ADA10. (F) Hypogranular granulocytic precursor and megaloblastoid erythroid precursor (arrows) in the marrow aspirate of patient ADA10. Biopsies were stained with hematoxylin and eosin and aspirates with Wright-Giemsa. Images were obtained via digital microscopy using an Olympus BX-51 microscope equipped with a DPlan 40×/0.65 numeric aperture objective and captured using an Olympus DP70 digital camera system. Adobe Photoshop CS3 was used to assemble the panels into one figure. (A,E) Original magnification ×40. (B,D,F) Original magnification ×1000. (C) Original magnification ×200.
The marrow aspirate of patient ADA6 showed marked eosinophilia (Figure 2B), consistent with his peripheral blood findings. Eosinophils were left-shifted, and some were hypogranular. Atypical trilineage maturation and dysplastic features were seen in all marrow samples. Hypolobular and unilobular megakaryocytes were present in all samples to a variable degree (Figure 2C-D). Patient ADA16 had multiple unilobular megakaryocytes on clot section. In addition, small clusters of megakaryocytes were observed. The marrow biopsy from patient ADA10 showed areas of atypical reticulin fibrosis with slightly increased numbers of mast cells in these areas (Figure 2E). Erythroid maturation was mildly megaloblastic in 4 of 5 cases (Table 3; Figure 2F). Rare normoblasts with nuclear budding were observed in one case.
Response to myelotoxic and myelostimulatory drugs
Patients ADA5, ADA10, ADA14, and ADA16 received busulfan chemotherapy (75-90 mg/m2 in 1 or 2 doses on 1 day), followed by the infusion of genetically corrected autologous bone marrow CD34+ cells, as part of an investigational protocol for the treatment of ADA-SCID.9,12 All patients had normal karyotypes before treatment. Absolute neutrophil counts (ANCs) were between 1000 and 4000 cells/μL in the months before gene therapy, although all were more than 1500 cells/μL before chemotherapy began. Busulfan areas under the curve ranged from 1451 to 3871 μM/min, which were within the expected pharmacokinetic values.
Patients ADA10, ADA14, and ADA16 had prolonged neutropenia (139, 59, and 37 days, respectively, until sustained ANC > 500 cells/μL independent of granulocyte colony-stimulating factor [G-CSF] treatment). In one patient who underwent chemotherapy with 2.9 mg/kg busulfan before gene therapy (ADA 14), a pretherapy biopsy at 14 months of age while still receiving PEG-ADA, was 50% cellular, whereas an evaluation 3 months after gene therapy showed 20%-30% cellularity and trilineage hypoplasia. All 3 patients ultimately were treated with granulocyte colony-stimulating factor (G-CSF) to achieve an ANC > 500 cells/μL. All 3 patients had brisk, but nonsustained, responses to G-CSF. Patients ADA14 and ADA16 each received 4 doses of G-CSF, both starting at ∼ 3 months after chemotherapy, whereas patient ADA10, who started growth factor support 2 months after transplantation, received 2 months of treatment. In each case, neutrophil counts increased promptly after a single dose of G-CSF but quickly fell to < 500 cells/μL, requiring further G-CSF doses (Figure 3). This pattern persisted in patients ADA14 and ADA16 for ∼ 1 month and in patient ADA10 for 2 months.
Response to G-CSF after low-dose busulfan conditioning. Arrows represent G-CSF doses. (A) Patient ADA10. (B) Patient ADA14. (C) Patient ADA16.
Response to G-CSF after low-dose busulfan conditioning. Arrows represent G-CSF doses. (A) Patient ADA10. (B) Patient ADA14. (C) Patient ADA16.
In addition to prolonged marrow suppression after low-dose busulfan, patients ADA10, ADA14, and ADA16 all developed neutropenia during treatment with antibiotics. Details of these episodes are shown in Table 4. The predominant drugs implicated were β-lactam antibiotics and vancomycin. Although the neutrophil nadirs were mild, the return to an ANC > 500 was typically prolonged, taking up to 74 days. Most of the episodes of antibiotic-induced neutropenia happened after gene therapy with low-dose conditioning, but in each such case, the interval between chemotherapy and antibiotic-associated neutropenia was at least 2 months, and in the most recent cases 4 years. One episode of antibiotic-induced neutropenia occurred before gene therapy.
Episodes of antibiotic-induced neutropenia
| Patient no. . | Indication for antibiotics . | Drugs . | Days after gene therapy at start of antibiotic treatment . | Baseline neutrophil count, cells/μL* . | Neutrophil nadir, cells/μL . | Time to neutrophil nadir, days . | Time to recovery of ANC to > 500 cells/μL without G-CSF, d . |
|---|---|---|---|---|---|---|---|
| ADA10 | Catheter exit site infection | Oxacillin, vancomycin | 84 | 1290 | 270 | 20 | 74 |
| ADA14 | Surgical prophylaxis | Cefazolin | 361 | 3677 | 764 | 1 | NA |
| ADA16 | S epidermidis bacteremia | Vancomycin; TMP/SFX, fluconazole acyclovir, rifampin, ethambutol, isoniazid, clarithromycin | Treatment started prior to gene therapy | 3023 | 449 | 31 | 37 |
| Pneumonia | Ceftriaxone, amoxicillin/clavulanic acid, azithromycin | 63 | 2858 | 373 | 14 | 15 | |
| Pneumonia/E coli bacteremia | Meropenem, amoxicillin/clavulanic acid azithromycin | 546 | 4620 | 387 | 11 | 37 | |
| Otitis media | Levofloxacin, Linezolid | 1463 | 1110 | 680 | 15 | NA | |
| Fever | Azithromycin | 1487 | 3490 | 490 | 2 | 6 |
| Patient no. . | Indication for antibiotics . | Drugs . | Days after gene therapy at start of antibiotic treatment . | Baseline neutrophil count, cells/μL* . | Neutrophil nadir, cells/μL . | Time to neutrophil nadir, days . | Time to recovery of ANC to > 500 cells/μL without G-CSF, d . |
|---|---|---|---|---|---|---|---|
| ADA10 | Catheter exit site infection | Oxacillin, vancomycin | 84 | 1290 | 270 | 20 | 74 |
| ADA14 | Surgical prophylaxis | Cefazolin | 361 | 3677 | 764 | 1 | NA |
| ADA16 | S epidermidis bacteremia | Vancomycin; TMP/SFX, fluconazole acyclovir, rifampin, ethambutol, isoniazid, clarithromycin | Treatment started prior to gene therapy | 3023 | 449 | 31 | 37 |
| Pneumonia | Ceftriaxone, amoxicillin/clavulanic acid, azithromycin | 63 | 2858 | 373 | 14 | 15 | |
| Pneumonia/E coli bacteremia | Meropenem, amoxicillin/clavulanic acid azithromycin | 546 | 4620 | 387 | 11 | 37 | |
| Otitis media | Levofloxacin, Linezolid | 1463 | 1110 | 680 | 15 | NA | |
| Fever | Azithromycin | 1487 | 3490 | 490 | 2 | 6 |
TMP/SFX indicates trimethoprim/sulfamethoxazole; and NA, not applicable.
Neutrophil count immediately before antibiotic treatment.
Effects of metabolic control on cell counts and morphology
Mature erythrocytes do not contain dAXP. When measured at the time of diagnosis in untransfused ADA-deficient patients, the magnitude of dAXP accumulation in red blood cells (here expressed as a percentage of total adenine nucleotides, see “Purine metabolic profile”) correlates with clinical severity.14 We have explored a possible relationship between this metabolic parameter and myeloid abnormality.
The erythrocytes of most patients receiving PEG-ADA had less than ∼ 2% dAXP, and there was no correlation between ANC and percentage dAXP in the patients on PEG-ADA (Figure 4A; P = .8369). In the subjects treated with gene therapy, the percentage dAXP increased after PEG-ADA withdrawal and busulfan conditioning, after which there was a statistically significant, inverse correlation between percentage dAXP and ANC (Figure 4B; P = .0012). For dAXP levels < 1%, there was no statistical difference in ANC between patients on PEG-ADA and those in whom PEG-ADA was withdrawn (Student t test, P = .42).
Plots of dAXP percentage versus ANC. (A) Samples drawn during routine evaluation. P = .8369. (B) Samples drawn from patients who had had chemotherapy followed by gene therapy, starting from one month after gene therapy. P = .0015. Measurements were taken up to 4 years after gene therapy. (C) Samples drawn at diagnosis of ADA-SCID, before institution of PEG-ADA therapy. P = .1312.
Plots of dAXP percentage versus ANC. (A) Samples drawn during routine evaluation. P = .8369. (B) Samples drawn from patients who had had chemotherapy followed by gene therapy, starting from one month after gene therapy. P = .0015. Measurements were taken up to 4 years after gene therapy. (C) Samples drawn at diagnosis of ADA-SCID, before institution of PEG-ADA therapy. P = .1312.
Another clinical situation where metabolic control is suboptimal is at diagnosis, before any specific treatment for ADA-SCID has been offered. In this setting, the ANCs tended to be lower as dAXPs were higher (Figure 4C; P = .1312), although the trend was not statistically significant, probably because of the small number of observations. These data may also be confounded somewhat by possible elevated ANCs because of infection at the time of diagnosis.
Discussion
Although the major hallmark of ADA deficiency is profound lymphopenia and the clinical presentation of SCID, it has also long been recognized that other tissues are more variably affected, emphasizing the systemic nature of this inborn metabolic disease.1-5 Our present findings suggest that the metabolic disorder also affects hematopoietic lineages other than the lymphoid series. We observed clear morphologic evidence of myeloid lineage dysplasia (including marrow hypocellularity, megaloblastic erythropoiesis, abnormal megakaryocytes, and dyspoietic cells in the peripheral blood; Tables 2–3).
We also observed multiple clinical sequelae of the myeloid abnormalities, including borderline low ANCs, drug-induced neutropenia, and increased susceptibility to busulfan-induced myelosuppression. The prolonged neutropenia seen in our patients after low-dose busulfan (confirmed by pharmacokinetics) is consistent with a myeloid deficiency.12
Importantly, we have demonstrated dysplasia in our patients' marrow both before (patients ADA5 and ADA10) and after (patients ADA14 and ADA16) chemotherapy, as well as in patients who never had chemotherapy (patients ADA1 and ADA6). Furthermore, peripheral blood abnormalities have been seen in patients who have undergone neither chemotherapy nor gene therapy (patients ADA3, ADA4, ADA5, ADA6, ADA7, ADA9, and ADA18). This points to the finding of dysplasia as being a primary problem of ADA-SCID, and not related to myelotoxic treatment or genotoxic complications.
Also supporting a primary myelotoxic mechanism of dysplasia is the inverse relationship, in the absence of PEG-ADA treatment, between dAXP percentage and ANC. In addition to elevated dAXP in erythrocytes, ADA deficiency may impose a metabolic burden on the marrow. The high levels of metabolites themselves may be toxic to myeloid cells and thus might represent the cause of dysmyelopoiesis. This relationship between ANC and dAXP is most seen in settings where the effects of PEG-ADA are absent for extended periods of time, such as at diagnosis or after gene therapy. In our experience the dAXP percentage starts to increase ∼ 5-10 days after PEG-ADA withdrawal. In the setting of ongoing treatment with PEG-ADA, elevated dAXP percentage may therefore represent either a few missed doses or suboptimal dosing. It is conceivable that these situations are reflected relatively quickly as an increase in the biochemical measurement of red blood cell dAXP percentage, whereas only prolonged exposure to the consequences of ADA deficiency results in the biologic effect represented by neutropenia.
An alternative and/or complementary hypothesis that could help explain our findings is that ADA deficiency may be associated with a stem cell defect. Indeed, the variety of dysplastic features seen in all hematopoietic lineages could reflect adenosine metabolite toxicity at the stem cell level and could explain the relative hypocellularity seen in the marrows of all patients for whom a core biopsy was performed. The existence of a stem cell defect in patients with ADA-SCID could also confer higher sensitivity to myelosuppressive chemotherapy and explain the relatively high levels of marking seen in gene therapy trials for this disease (∼ 5%) after relatively low-dose conditioning.11
Of note, several of our patients were being treated with PEG-ADA at the time of this study, and many had normal or nearly normal levels of dAXPs. Nevertheless, every patient had at least peripheral blood evidence of myeloid dysplasia, thus indicating that correction of the peripheral blood ADA substrate levels does not ameliorate such abnormalities. This is consistent with the partial restoration of immunity associated with PEG-ADA therapy.15,16
Several important clinical issues are raised by our findings. First, the fact that ADA-SCID negatively affects both the lymphoid and myeloid systems is a further argument for using CD34-directed, rather than lymphocyte-directed, approaches in trials of gene therapy for ADA-SCID. Moreover, risks of severe and prolonged neutropenia should be considered in patients with ADA-SCID, especially if chemotherapy, antibiotics, and other potentially myelotoxic medications are planned or likely. Indeed, 4 of 6 patients treated with busulfan in our series showed prolonged neutropenias.9,12 Similarly, 2 patients in the study of Aiuti et al had prolonged times until recovery of neutrophil counts.11 In addition, 2 of our patients showed apparent sensitivity to β-lactam antibiotics. Therefore, patients with ADA-SCID who require antibiotics should be monitored closely for the possible development of neutropenia. In addition, consideration should be given for growth factor support in patients with apparent medication-associated neutropenia.
Finally, the relationship of our findings to myelodysplastic syndrome is not clear. It must be emphasized that while all of our patients have had myeloid dysplasia, none met the diagnostic criteria for myelodysplastic syndrome.17 However, a patient treated previously in our trial did develop prolonged and severe pancytopenia that ultimately required allogeneic hematopoietic cell transplantation. This patient was later found to have had a preexisting trisomy 8.9 In light of the current findings, the potential for patients with ADA-SCID to develop frank myelodysplastic syndrome is raised.
In conclusion, we have shown that ADA-SCID is associated with myeloid dysplasia and that this association leads to clinically important consequences in the treatment of this systemic disorder. As management options for ADA-SCID, both novel and conventional, expand, these findings may impact clinical and investigational decision-making.
The publication costs of this article were defrayed in part by page charge payment. Therefore, and solely to indicate this fact, this article is hereby marked “advertisement” in accordance with 18 USC section 1734.
Acknowledgments
The authors thank the contributions of the patients and their families, referring physicians and medical care teams, and the faculty and staff of the National Human Genome Research Institute, the National Institutes of Health Clinical Center, and the National Cancer Institute; Drs Steven Pavletic, Claude Sportes, and Suk See DeRavin for the provision of peripheral blood smears from patients treated with TMP/SFX; Mr Neal Oden for statistical help; and Ms Julia Fekecs for assistance in preparing the figures.
This work was supported by the intramural research programs of the National Human Genome Research Institute, the NCI Center for Cancer Research, and the NIH Clinical Center. M.S.H. and P.B. received support from Enzon Inc. I.C.H. was supported by the National Institute of Allergy and Infectious Diseases.
National Institutes of Health
Authorship
Contribution: R.S. provided clinical care to the patients, examined blood smears and marrow biopsies, collected data, and wrote the manuscript; I.M. examined blood smears and marrow biopsies, prepared figures, and wrote the manuscript; C.K., E.G., I.C.H., A.S.W., and F.C. provided clinical care; C.K. and A.S.W. examined peripheral blood smears and marrow biopsies; M.S.H. and P.B. performed biochemical analyses; M.D., R.B., A.C.I., N.K., K.S., and B.T. provided clinical data; D.B.K. interpreted data; F.C. directed the research; and all authors revised the manuscript.
Conflict-of-interest disclosure: I.C.H. has consulted for CSL. M.S.H. is a consultant for Sigma-Tau. The remaining authors declare no competing financial interests.
Correspondence: Robert Sokolic, Disorders of Immunity Section, National Human Genome Research Institute, 10 Center Dr, Bldg 10CRC, Rm 6-3330, MSC 1611, Bethesda, MD 20892; e-mail: sokolicr@mail.nih.gov.

This feature is available to Subscribers Only
Sign In or Create an Account Close Modal